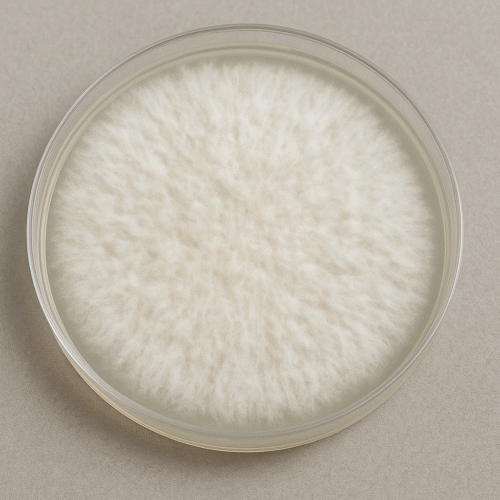
ChatGPT Image 24 oct 2025, 16_21_18 Tablas Petri

Sobre Nosotros
Somos EcaMushrooms y transformamos el bienestar mental a través de la integración segura y efectiva del uso de hongos medicinales en la ciencia moderna, promoviendo una vida más equilibrada, consciente y plena para todos.
¿Como lo hacemos?
Desarrollamos y proporcionamos productos de alta calidad y científicamente respaldados, centrándonos en la salud mental y el bienestar emocional de nuestros clientes.
Tratamientos
Nos comprometemos con ofrecer tratamientos innovadores, económicamente accesibles y seguros, mientras educamos y apoyamos a la comunidad en la comprensión y el uso responsable de dichos tratamientos como herramienta terapéutica.
TIENDA
ECA BLOGS

Beneficios de una Ceremonia de Niños Santos con Cacao
Continuar leyendoBeneficios de una Ceremonia de Niños Santos con Cacao
Sabiduría Ancestral; Teonanacatl y Cacao
Continuar leyendoSabiduría Ancestral; Teonanacatl y Cacao